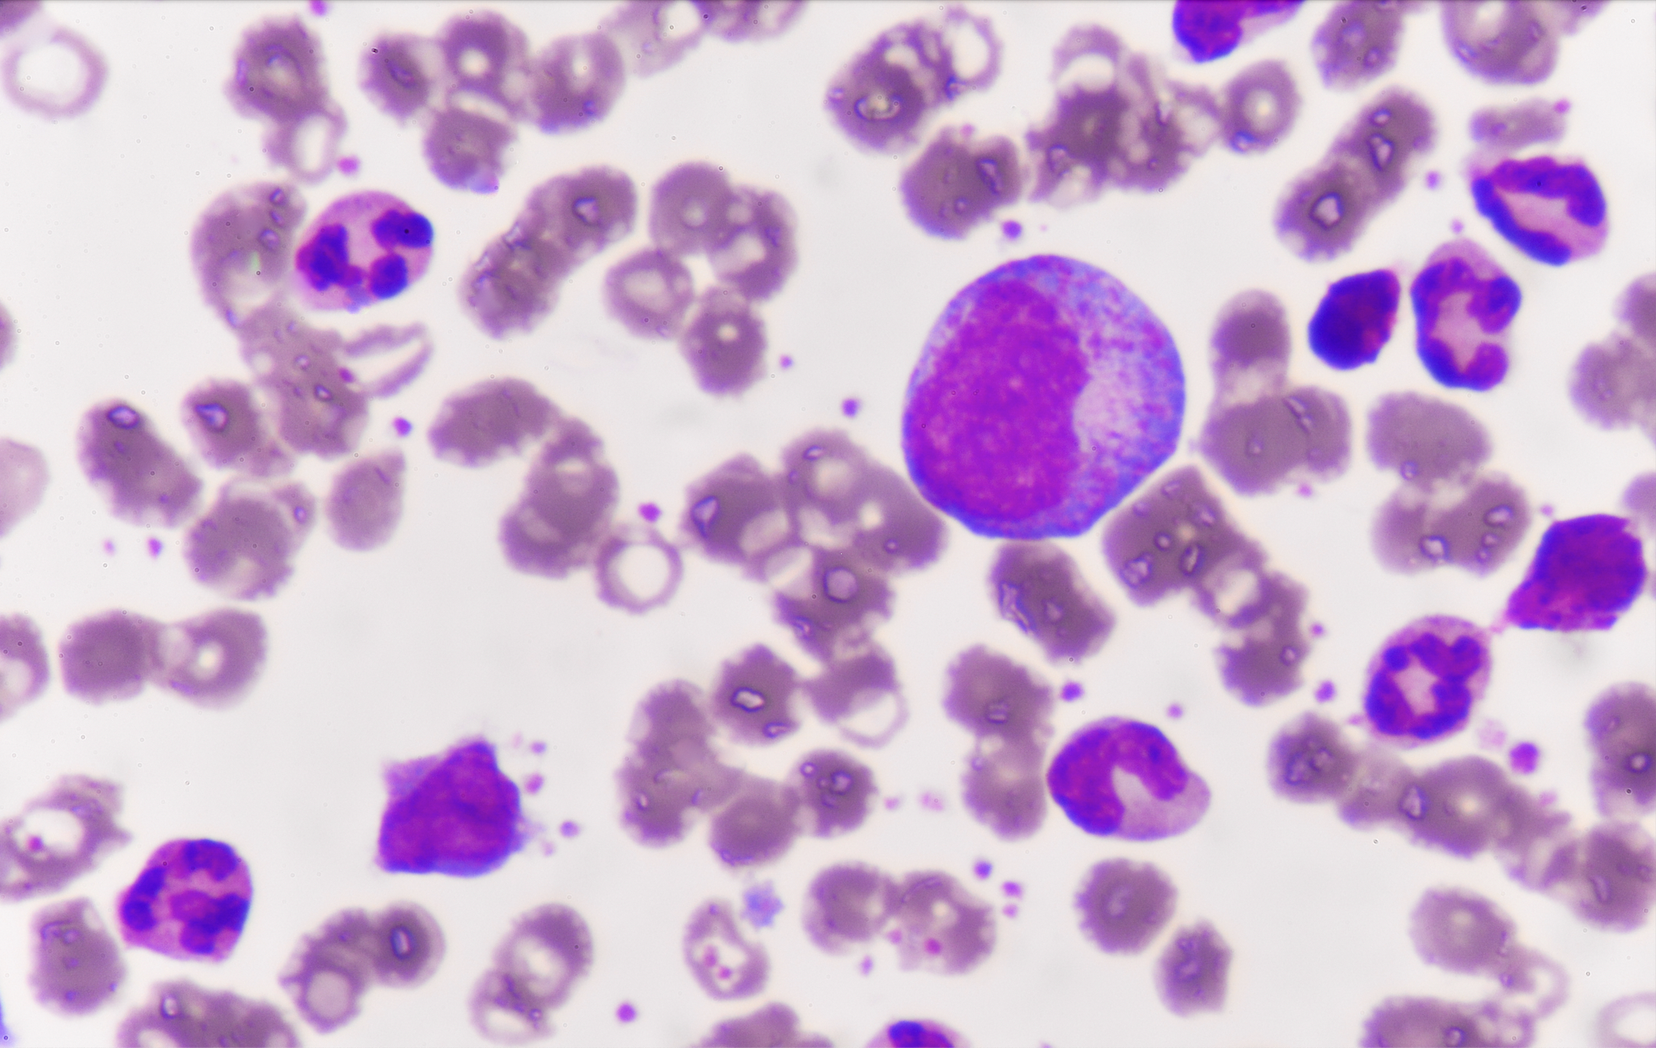
Leukemia

You're currently viewing OncGenius as a guest. To save your results, create an account or log in.
CategoriesView All Quizzes
Tumor Type
- Breast Cancer
- Gastrointestinal Cancers
- Genitourinary Cancers
- Gynecologic Cancers
- Head & Neck/Thyroid Cancer
- Leukemia
- Lung Cancer
- Lymphoma
- Melanoma
- Multiple Myeloma
- Neuro-oncology
Additional Topics
Conference Coverage
- 2024 ASH Annual Meeting & Exposition
- 2021 ASH Annual Meeting & Exposition
- 2021 San Antonio Breast Cancer Symposium
- 2022 ASCO Annual Meeting
- 2022 ASCO Gastrointestinal Cancers Symposium
- 2022 ASCO Genitourinary Cancers Symposium
- 2022 ASCO Quality Care Symposium
- 2022 ASH Annual Meeting and Exposition
- 2022 Multidisciplinary Head and Neck Cancers Symposium
- 2022 San Antonio Breast Cancer Symposium
- 2023 ASCO Annual Meeting
- 2023 ASCO Gastrointestinal Cancers Symposium
- 2023 ASCO Genitourinary Cancers Symposium
- 2023 ASH Annual Meeting and Exposition
- 2023 San Antonio Breast Cancer Symposium
- 2024 ASCO Annual Meeting
- 2024 ASCO Gastrointestinal Cancers Symposium
- 2024 ASCO Genitourinary Cancers Symposium
- 2025 AACR Annual Meeting
- 2025 ASCO Annual Meeting
- 2025 ASCO Gastrointestinal Cancers Symposium
- 2025 ASCO Genitourinary Cancers Symposium
- AACR Annual Meeting 2022
- AACR Annual Meeting 2023
- ASTRO Annual Meeting 2022
- ESMO Congress 2022
- ESMO Congress 2023
- ESMO Congress 2024